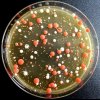
2222.jpg
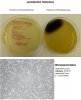
Lb.jpg
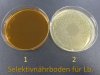
Lb.jpg

Du verwendest einen veralteten Browser. Es ist möglich, dass diese oder andere Websites nicht korrekt angezeigt werden.
Du solltest ein Upgrade durchführen oder einen alternativen Browser verwenden.
Du solltest ein Upgrade durchführen oder einen alternativen Browser verwenden.
G
Gelöschtes Mitglied 9419
Guest
G
Gelöschtes Mitglied 9419
Guest
Hallo
Bekannter Weise läuft die Vorfilterung an meinem Teich durch zwei Filtoclear 15‘000. Natürlich ergibt sich durch diese Technik kein partikelfreies Wasser, was mich und anscheinend auch meine Koi nicht stört. Ich reinige diese Filter mittels Hebelfunktion regelmässig und bemerkte immer wieder wie kleine Schaumstoffteilchen ausgespült wurden.
Oase empfiehlt diese Schwämme jährlich zu ersetzen. Na ja, nach sieben Jahren dachte ich es wäre nun wirklich an der Zeit dies zu tun und kaufte im Sommer 2016 zwei neue Set.
Ich staunte nicht schlecht oder besser gesagt, ich bin erschrocken. Auf dem Bild ist ein neues Set an Schwämmen für einen Filtoclear zu sehen und darunter was von meinen zwei „Vorfilter“ noch übrig geblieben ist.
Wenn ich die durchschnittlichen Keimzahlen vor und nach der Auswechslung der Schwämme vergleiche, kann ich berichten dass sich die GKZ mit dem neuen Material um 22% gesenkt hat. Es spielt jedoch keine Rolle ob ich nun 4‘000 oder 3‘000 KBE/ml im Teichwasser habe, das ist „Hans was Heinrich“. Darum werde ich die Schwämme wohl erst wieder im Jahre 2023 ersetzen.
:wink:
Gruss Dany
Bekannter Weise läuft die Vorfilterung an meinem Teich durch zwei Filtoclear 15‘000. Natürlich ergibt sich durch diese Technik kein partikelfreies Wasser, was mich und anscheinend auch meine Koi nicht stört. Ich reinige diese Filter mittels Hebelfunktion regelmässig und bemerkte immer wieder wie kleine Schaumstoffteilchen ausgespült wurden.
Oase empfiehlt diese Schwämme jährlich zu ersetzen. Na ja, nach sieben Jahren dachte ich es wäre nun wirklich an der Zeit dies zu tun und kaufte im Sommer 2016 zwei neue Set.
Ich staunte nicht schlecht oder besser gesagt, ich bin erschrocken. Auf dem Bild ist ein neues Set an Schwämmen für einen Filtoclear zu sehen und darunter was von meinen zwei „Vorfilter“ noch übrig geblieben ist.
Wenn ich die durchschnittlichen Keimzahlen vor und nach der Auswechslung der Schwämme vergleiche, kann ich berichten dass sich die GKZ mit dem neuen Material um 22% gesenkt hat. Es spielt jedoch keine Rolle ob ich nun 4‘000 oder 3‘000 KBE/ml im Teichwasser habe, das ist „Hans was Heinrich“. Darum werde ich die Schwämme wohl erst wieder im Jahre 2023 ersetzen.
:wink:
Gruss Dany
Anhänge
G
Gelöschtes Mitglied 9419
Guest
Hallo zusammen
Das Angebot von Nährböden zur Hygienekontrolle ist gross und für den Koihalter verlockend. So könnten beispielsweise Spezial –Agars zur Ermittlung von Aeromonas oder Pseudomonas bestellt werden um Abstriche des kranken Koi zu kultivieren, Diagnose zu stellen und den Fisch auch gleich selber zu behandeln. Dies wäre doch super und absoluter Luxus am Teich.
Wieso dies der Koihalter nicht tun sollte, habe ich auf Seite 25 in diesem Thread schon einmal beschrieben. Auf Grund aktueller Bewegungen hinter der Bühne des „Keimzahl Thread‘s“, möchte ich mit einem Beispiel aus meinem Arbeitsalltag noch einmal auf die Problematik beim Einsatz von Selektivnährböden hinweisen.
Im beschriebenen Fall handelt sich um einen Selektivnährboden für Enterokokken, bekannt auch unter dem Namen Fäkalstreptokokken. Mit diesem Agar kann eine bestehende Verunreinigung fäkalen Ursprungs nachgewiesen werden. In meinem Teichwasser zurzeit pro KBE/ml noch nicht nachweisbar. Unten habe ich Ausschnitte aus dem Produktebeschrieb eingestellt, die ganz klar den Verwendungszweck dieses Nährbodens festlegen.
Auch ist bei der Beurteilung des Resultates beschrieben welche Farbe Enterokokken Kolonien auf diesem Nährboden entwickeln. Nämlich rot und dies ist auch mit einem Bild auf dem Beschrieb festgehalten. Es wird auf die Begleitflora hingewiesen, die farblose oder violette Kolonien bilden wird. Ein schön farbiger Produktebeschrieb bei dem es eigentlich keine Fragen gibt.
Es war ein kleiner Produktionsbetrieb für Lebensmittel, eingerichtet mit einer „Laborecke“ wo auch einfache bakteriologische Untersuchungen zur Sicherung der Qualität durchgeführt wurden. Eines der Endprodukt aus diesem Betrieb, war nach Aussage des Betriebsleiters immer mit Enterokokken belastet was natürlich verunsicherte. Etliche Anstrengungen wurden schon gemacht um diese unerwünschte Keimbelastung zu beseitigen und das Produkt endlich freizugeben.
Nun, wir erhielten ein solches Produkt um dieses auf Enterokokken zu testen. Der Befund schien positiv und die Bakterienkolonien zeigten sich wie auf dem Produktebeschrieb in einem vorbildlichen rot. Auch der mikroskopische Befund war klar aber die Höhe des Resultates mit mehreren 100‘000 KBE/ml Enterokokken war nachdenklich hoch und für die untersuchte Probe ungewöhnlich. Im Zweifelsfall gibt es Bestätigungs-Nährböden für Enterokokken, die im genannten Beispiel zum Einsatz kamen.
Dabei wird die verdächtige Kolonie auf dem Agar ausgestrichen, inkubiert und das Bakterienwachstum durch eine Schwarzfärbung als Enterokokken positiv bestätigt. Die präsumtiven (verdächtigen) Kolonien waren allesamt negativ. Für den Kunden ein erfreuliches Resultat und für das Laborpersonal ein „Wink“, steht’s aufmerksam und kritisch zu bleiben. Die Identifikation ergab Lactococcus sp. die im mikroskopischen Vergleich, schwer von Enterokokken zu unterscheiden sind. Es ist etwas tragisch aber die Verantwortlichen dieses Kleinbetriebes hatten bereits den Kampf gegen ihr eigenes Impfgut aufgenommen!
Ich konnte meiner Neugier nicht wiederstehen und beimpfte diesen Selektivnährboden für den Nachweis von Enterkokokken mit verschieden Keimen, unter anderem mit Bifidobakterien und Lactobacillus rhamnosus. Diese Keime sind beliebte Probiotikazusätze für gutes Wasser und Gesundheit der Koi. Der Bifidus wuchs auf diesem Nährboden etwas gehemmt aber in beschriebenem „Enterokokkenrot“, war jedoch auf dem Bestätigungsagar negativ. Gut so! Der Lb. rhamnosus jedoch, schlug mit vollem Wachstum durch und bestätigte sich auch noch als Enterococcus.????????
Ausschnitte aus der Stellungsname des Herstellers zeigten sich bescheiden und lauteten wie folgt:
„Lactococcus sp. und Lactobacillus rhamnosus gehören bis dato nicht zum Prüfumfang des genannten Mediums. Werden somit nicht spezifiziert.
Im Datenblatt steht explizit geschrieben, dass die Bestandteile des Mediums die meiste Begleitflora (neben den Enterokokken) hemmt, aber eben nicht vollständig.
Der Kunde ist bei unklaren Ergebnissen auch immer in der Pflicht weitere selektive Bestätigungsmedien einzusetzen, um die Organismen weiter zu charakterisieren bzw. zu identifizieren,
wie es im vorliegenden Fall auch geschehen ist.
In unserer QC werden nun Lactococcus sp. und Lb. Rhamnosus Stämme auf diesem Medium angeschaut hinsichtlich der farblichen Unterschiede.
Wir hoffen damit geholfen zu haben.“
Dieses Beispiel wird sich auch bei Selektiv-Nährböden zur Ermittlung von Aeromonas oder Pseudomonas wiederholen und darum empfehle ich den Einsatz von solchen Spezial-Nährböden für fachunkundige Personen nicht. Verabreichungen von Antibiotika bei falscher Diagnose, fördert nicht die Gesundheit des Koi sondern die Resistenz von Bakterien gegenüber solcher Substanzen.
Wenn sich der Koihalter mit der Bakterienwelt befassen will, soll er sich nur mit der Ermittlung der Gesamtkeimzahl seines Teichwassers beschäftigen, dann hat er schon viel für die Gesundheit und dem Wohlergehen seiner Koi beigetragen!
Informationen zu diesem Thema gibt es in diesem Thread zur Genüge, man muss es nur lesen.
Gruss Dany
Das Angebot von Nährböden zur Hygienekontrolle ist gross und für den Koihalter verlockend. So könnten beispielsweise Spezial –Agars zur Ermittlung von Aeromonas oder Pseudomonas bestellt werden um Abstriche des kranken Koi zu kultivieren, Diagnose zu stellen und den Fisch auch gleich selber zu behandeln. Dies wäre doch super und absoluter Luxus am Teich.
Wieso dies der Koihalter nicht tun sollte, habe ich auf Seite 25 in diesem Thread schon einmal beschrieben. Auf Grund aktueller Bewegungen hinter der Bühne des „Keimzahl Thread‘s“, möchte ich mit einem Beispiel aus meinem Arbeitsalltag noch einmal auf die Problematik beim Einsatz von Selektivnährböden hinweisen.
Im beschriebenen Fall handelt sich um einen Selektivnährboden für Enterokokken, bekannt auch unter dem Namen Fäkalstreptokokken. Mit diesem Agar kann eine bestehende Verunreinigung fäkalen Ursprungs nachgewiesen werden. In meinem Teichwasser zurzeit pro KBE/ml noch nicht nachweisbar. Unten habe ich Ausschnitte aus dem Produktebeschrieb eingestellt, die ganz klar den Verwendungszweck dieses Nährbodens festlegen.
Auch ist bei der Beurteilung des Resultates beschrieben welche Farbe Enterokokken Kolonien auf diesem Nährboden entwickeln. Nämlich rot und dies ist auch mit einem Bild auf dem Beschrieb festgehalten. Es wird auf die Begleitflora hingewiesen, die farblose oder violette Kolonien bilden wird. Ein schön farbiger Produktebeschrieb bei dem es eigentlich keine Fragen gibt.
Es war ein kleiner Produktionsbetrieb für Lebensmittel, eingerichtet mit einer „Laborecke“ wo auch einfache bakteriologische Untersuchungen zur Sicherung der Qualität durchgeführt wurden. Eines der Endprodukt aus diesem Betrieb, war nach Aussage des Betriebsleiters immer mit Enterokokken belastet was natürlich verunsicherte. Etliche Anstrengungen wurden schon gemacht um diese unerwünschte Keimbelastung zu beseitigen und das Produkt endlich freizugeben.
Nun, wir erhielten ein solches Produkt um dieses auf Enterokokken zu testen. Der Befund schien positiv und die Bakterienkolonien zeigten sich wie auf dem Produktebeschrieb in einem vorbildlichen rot. Auch der mikroskopische Befund war klar aber die Höhe des Resultates mit mehreren 100‘000 KBE/ml Enterokokken war nachdenklich hoch und für die untersuchte Probe ungewöhnlich. Im Zweifelsfall gibt es Bestätigungs-Nährböden für Enterokokken, die im genannten Beispiel zum Einsatz kamen.
Dabei wird die verdächtige Kolonie auf dem Agar ausgestrichen, inkubiert und das Bakterienwachstum durch eine Schwarzfärbung als Enterokokken positiv bestätigt. Die präsumtiven (verdächtigen) Kolonien waren allesamt negativ. Für den Kunden ein erfreuliches Resultat und für das Laborpersonal ein „Wink“, steht’s aufmerksam und kritisch zu bleiben. Die Identifikation ergab Lactococcus sp. die im mikroskopischen Vergleich, schwer von Enterokokken zu unterscheiden sind. Es ist etwas tragisch aber die Verantwortlichen dieses Kleinbetriebes hatten bereits den Kampf gegen ihr eigenes Impfgut aufgenommen!
Ich konnte meiner Neugier nicht wiederstehen und beimpfte diesen Selektivnährboden für den Nachweis von Enterkokokken mit verschieden Keimen, unter anderem mit Bifidobakterien und Lactobacillus rhamnosus. Diese Keime sind beliebte Probiotikazusätze für gutes Wasser und Gesundheit der Koi. Der Bifidus wuchs auf diesem Nährboden etwas gehemmt aber in beschriebenem „Enterokokkenrot“, war jedoch auf dem Bestätigungsagar negativ. Gut so! Der Lb. rhamnosus jedoch, schlug mit vollem Wachstum durch und bestätigte sich auch noch als Enterococcus.????????
Ausschnitte aus der Stellungsname des Herstellers zeigten sich bescheiden und lauteten wie folgt:
„Lactococcus sp. und Lactobacillus rhamnosus gehören bis dato nicht zum Prüfumfang des genannten Mediums. Werden somit nicht spezifiziert.
Im Datenblatt steht explizit geschrieben, dass die Bestandteile des Mediums die meiste Begleitflora (neben den Enterokokken) hemmt, aber eben nicht vollständig.
Der Kunde ist bei unklaren Ergebnissen auch immer in der Pflicht weitere selektive Bestätigungsmedien einzusetzen, um die Organismen weiter zu charakterisieren bzw. zu identifizieren,
wie es im vorliegenden Fall auch geschehen ist.
In unserer QC werden nun Lactococcus sp. und Lb. Rhamnosus Stämme auf diesem Medium angeschaut hinsichtlich der farblichen Unterschiede.
Wir hoffen damit geholfen zu haben.“
Dieses Beispiel wird sich auch bei Selektiv-Nährböden zur Ermittlung von Aeromonas oder Pseudomonas wiederholen und darum empfehle ich den Einsatz von solchen Spezial-Nährböden für fachunkundige Personen nicht. Verabreichungen von Antibiotika bei falscher Diagnose, fördert nicht die Gesundheit des Koi sondern die Resistenz von Bakterien gegenüber solcher Substanzen.
Wenn sich der Koihalter mit der Bakterienwelt befassen will, soll er sich nur mit der Ermittlung der Gesamtkeimzahl seines Teichwassers beschäftigen, dann hat er schon viel für die Gesundheit und dem Wohlergehen seiner Koi beigetragen!
Informationen zu diesem Thema gibt es in diesem Thread zur Genüge, man muss es nur lesen.
Gruss Dany
Anhänge
Petro Wendelstain
Mitglied
Tolle Anmerkung. Nur leider völlig daneben. Beweis für : "Ich weiss (leider nicht) dass ich nichts weiss."
Petro
Petro
G
Gelöschtes Mitglied 9419
Guest
Hallo
und noch ein Beispiel von letzter Woche.
Abgebildet zwei Selektivnährböden für die Ermittlung von Lactobacillus, beimpft mit dem Spiralplatten - Verfahren. In der Koihaltung interessant wenn es um probiotische Ergänzungen des Futters geht. Ein Kunde bat uns diese zu vergleichen. Es wurden verschiedenste Ansätze untersucht und man darf berichten dass auf beiden Nährböden auch wirklich Lactobacillus wächst.
In leichtes Staunen und „Schmuntzeln“ versetzte uns jedoch das Ergebnis der abgebildeten Platten. Bei diesem Untersuch war die Probe frei von Laktobazillen obwohl Platte 2 mit Kolonien voll belegt ist. Bacillus = Stäbchen und alle Bakterien die diesen Namen tragen, haben die Form eines Stäbchens. Die Mikroskopie des Wachstums zeigte ganz klar kokkenförmige (Kugel) Bakterienzellen, womit Nährboden 2 nicht wirklich selektiv ist und Nr. 1 ein verlässliches Resultat liefert.
Ohne Fachkenntnisse und Erfahrung wären auch hier wieder Falschresultate und folgend Falschinterpretationen an der Tagesordnung gewesen.
Diese Beispiele zeigen aber auch, wieso sich viele nicht an bakteriologische Analysen am Teich getrauen. Ohne Fachkenntnisse befindet man sich bei erweiterten mikrobiologischen Aufgaben im Nirgendwo und der Schaden durch falsche Beurteilungen könnte schnell grösser sein als der Nutzen!
Halten wir uns nur an die Ermittlung der Wasserhygiene im Teich, ist dies mit einem entsprechenden Nährboden wie dem PCA (Plate Count Agar) ohne Hexerei und nur mit „Pünktchen“ zählen verlässlich machbar.
Gruss Dany
und noch ein Beispiel von letzter Woche.
Abgebildet zwei Selektivnährböden für die Ermittlung von Lactobacillus, beimpft mit dem Spiralplatten - Verfahren. In der Koihaltung interessant wenn es um probiotische Ergänzungen des Futters geht. Ein Kunde bat uns diese zu vergleichen. Es wurden verschiedenste Ansätze untersucht und man darf berichten dass auf beiden Nährböden auch wirklich Lactobacillus wächst.
In leichtes Staunen und „Schmuntzeln“ versetzte uns jedoch das Ergebnis der abgebildeten Platten. Bei diesem Untersuch war die Probe frei von Laktobazillen obwohl Platte 2 mit Kolonien voll belegt ist. Bacillus = Stäbchen und alle Bakterien die diesen Namen tragen, haben die Form eines Stäbchens. Die Mikroskopie des Wachstums zeigte ganz klar kokkenförmige (Kugel) Bakterienzellen, womit Nährboden 2 nicht wirklich selektiv ist und Nr. 1 ein verlässliches Resultat liefert.
Ohne Fachkenntnisse und Erfahrung wären auch hier wieder Falschresultate und folgend Falschinterpretationen an der Tagesordnung gewesen.
Diese Beispiele zeigen aber auch, wieso sich viele nicht an bakteriologische Analysen am Teich getrauen. Ohne Fachkenntnisse befindet man sich bei erweiterten mikrobiologischen Aufgaben im Nirgendwo und der Schaden durch falsche Beurteilungen könnte schnell grösser sein als der Nutzen!
Halten wir uns nur an die Ermittlung der Wasserhygiene im Teich, ist dies mit einem entsprechenden Nährboden wie dem PCA (Plate Count Agar) ohne Hexerei und nur mit „Pünktchen“ zählen verlässlich machbar.
Gruss Dany
Anhänge
G
Gelöschtes Mitglied 9419
Guest
Hallo
Vor einiger Zeit kontaktierte mich ein User und berichtete mir über seine damals bakteriologischen Probleme bei den Fischen.
Er machte sich Gedanken über die Möglichkeiten den Teich im Frühling oder Vorsommer etwas aufzuheizen. Er verlegte deshalb auf dem Garagendach eine mehrere Meter lange Gartenschlauch-Schlange, die er mit Wasser füllte und an der Sonne erwärmen liess, um sie schliesslich im Teich immer wieder zu entleeren. Eigentlich eine sinnvolle Idee um Energie zu sparen. Der Koihalter unterschätzte jedoch die Keimvermehrung in diesem „stehenden Gewässer“, das mit dem Schlauch ein Brutschrankeffekt aufwies.
Ich befüllte meinen 20 Meter langen Gartenschlauch, der fast täglich seinen Einsatz findet und somit gut durchspült ist, mit Leitungswasser und liess in knapp 48 Stunden im Garten liegen. Die Lufttemperatur gegen 28°C. Zugleich faste ich eine Wasserprobe ab Hahn (Gartenanschluss) die sogleich untersucht wurde. Sie wies die Belastung der aeroben mesophilen Keimzahl von 64 KBE/ml auf. Dies ist eine relativ hohe Zahl aber nicht verwunderlich, da dieser Wasserhahn seinen Platz draussen im Garten hat.
Die Probe des Schlauches protzte nach knapp zwei Tagen „Bebrütung“ mit der Zahl von 210‘000 KBE/ml.
Beim oben erwähnten Fall wurde das Teichwasser scheinbar immer wieder frisch beimpft, bis der Keimdruck schliesslich zu hoch wurde und die Koi dementsprechend reagierten und vom KoiDoc behandelt werden mussten.
Wie das restliche Teichmanagement jedoch aussah weiss ich nicht aber nach dem Unterlassen dieser Teicherwärmung gab es keine Bakteriengeschichten mehr.
Wäre aber an diesem Teich die selbständige Erfassung des Keimdruckes mit DipSlides (PC-Agar) bereits Routine gewesen, hätte man auch hier diese steigende Keimbelastung rechtzeitig erkannt und dagegen steuern können.
Gruss Dany
Vor einiger Zeit kontaktierte mich ein User und berichtete mir über seine damals bakteriologischen Probleme bei den Fischen.
Er machte sich Gedanken über die Möglichkeiten den Teich im Frühling oder Vorsommer etwas aufzuheizen. Er verlegte deshalb auf dem Garagendach eine mehrere Meter lange Gartenschlauch-Schlange, die er mit Wasser füllte und an der Sonne erwärmen liess, um sie schliesslich im Teich immer wieder zu entleeren. Eigentlich eine sinnvolle Idee um Energie zu sparen. Der Koihalter unterschätzte jedoch die Keimvermehrung in diesem „stehenden Gewässer“, das mit dem Schlauch ein Brutschrankeffekt aufwies.
Ich befüllte meinen 20 Meter langen Gartenschlauch, der fast täglich seinen Einsatz findet und somit gut durchspült ist, mit Leitungswasser und liess in knapp 48 Stunden im Garten liegen. Die Lufttemperatur gegen 28°C. Zugleich faste ich eine Wasserprobe ab Hahn (Gartenanschluss) die sogleich untersucht wurde. Sie wies die Belastung der aeroben mesophilen Keimzahl von 64 KBE/ml auf. Dies ist eine relativ hohe Zahl aber nicht verwunderlich, da dieser Wasserhahn seinen Platz draussen im Garten hat.
Die Probe des Schlauches protzte nach knapp zwei Tagen „Bebrütung“ mit der Zahl von 210‘000 KBE/ml.
Beim oben erwähnten Fall wurde das Teichwasser scheinbar immer wieder frisch beimpft, bis der Keimdruck schliesslich zu hoch wurde und die Koi dementsprechend reagierten und vom KoiDoc behandelt werden mussten.
Wie das restliche Teichmanagement jedoch aussah weiss ich nicht aber nach dem Unterlassen dieser Teicherwärmung gab es keine Bakteriengeschichten mehr.
Wäre aber an diesem Teich die selbständige Erfassung des Keimdruckes mit DipSlides (PC-Agar) bereits Routine gewesen, hätte man auch hier diese steigende Keimbelastung rechtzeitig erkannt und dagegen steuern können.
Gruss Dany
G
Gelöschtes Mitglied 9419
Guest
Hallo
Ich beende dieses Jahr nun bereits meine 9. Koisaison. Als ich meinen Teich im Herbst 2008 das erste Mal mit Wasser befüllte und im folgenden Frühling mit Koi besetzte, da war die Verunsicherung bei mir gross. Aus der Fachliteratur, der Teichberatungen bei Koihändlern oder aus den vielen Erfahrungsberichten in Foren, interpretierte ich die Koihaltung als eine herausfordernde und anstrengende Gratwanderung. Falsches Handeln am Teich könnte für die Koi verheerende Folgen haben und die Kosten für die Behebung möglicher Fehler beim Teichbau, sowie die Rechnungen tierärztlicher Behandlungen, wären alles andere als entspannend.
Bei meinem ersten Kurs beim FishDoc lernte ich bereits auf dem Parkplatz einen Kursteilnehmer kennen. Dieser berichtete mir über den Tod seines gesamten Koibestandes durch Sauerstoffmangel und dies im ersten Sommer. Ich sah in diesem Moment meine Interpretation über die Koihaltung als bestätigt. Beruhigend war für mich, dass ich selber Kursteilnehmer war und das Gelernte mit bestem Willen auch in die Tat umsetzen wollte. Ja, mit allen guten Vorsätzen……………………………..ich habe schlussendlich doch nicht alles so umgesetzt wie mir empfohlen wurde.
Bei meiner bescheidenen Anlage ist zwar gutes Material im Einsatz aber meine Filteranlage ist nicht „high Tech“. Meine Vorfilterung wird nie Partikel- oder Schwebeteilchen freies Wasser freigeben und der Flow in meinem Teich ist mit 3 Stunden und 20 Minuten überhaupt nicht das, was empfohlen wird. Mein Teichwasser erfüllt aber die Sollwerte der gängigen und wichtigsten Parameter einer Koihaltung.
Es ist nicht so dass meine Filtertechnik eventuelle Abweichungen der Wasserwerte von alleine korrigiert. Ein pflichtbewusstes Teichmanagement lässt mich Verschiebungen frühzeitig erkennen und Gegenmassnahmen einleiten.
Auch die Veränderungen des Keimdruckes im freien Wasser, sei es temperaturbedingt, Futtermenge, Probleme der Vorfilterung oder verbrauchte UV-Lampen, lassen sich mit DipSlides einfach und verlässlich feststellen. Für mich ist es wichtig zu sehen wie meine Anlage arbeitet und so testete ich wieder einmal die Keimbelastungen der Stationen meiner Filterung. Ich erhalte so Daten die mir zeigen ob alles im gewohnten Rahmen abläuft. Diese Stufenkontrolle fasste ich mit je 3 Proben pro Sektor während der Hitzeperiode im August des vergangenen Sommers.
Eindrücklich ist die Belastung des Spülwassers der Filtoclear, die bei mir als Vorfilterung immer noch ihren Dienst leisten. Bei diesen Filtern spüle ich das Wasser mittels Hebelfunktion alle zwei Wochen aus. Gäbe es keine Grobschmutzabsonderung müsste der gesammelte organische Abfall im Teich vermodern und die Keimzahl würde ansteigen.
Verlässt das Wasser die Filtoclear, wird es über zwei Einläufe in die 1. Biokammer geleitet. Um restliche Grobpartikel abzufangen, sind die beiden Einläufe mit Strümpfen versehen. Folgend ist noch eine Japanmatte positioniert, bevor das Wasser die belüfteten und mit Helix befüllten Kammern passiert. Das Wasser der Kammern zeigt sich gleich belastet wie jenes im Teich. Dies beruhigt mich, denn eine hohe Zahl könnte für die Nitrifikanten störend sein.
Die Bakterienbelastung in meiner UV-Kammer zeigt sich tief. Meine Tauch-UVC-eco- Fish 60 Watt Amalgam, senkt die Keimzahl auch mit 10‘230 Betriebsstunden noch einwandfrei. Auf der Skizze ist zu sehen dass ich nicht alles Wasser durch die UV behandeln lasse. 1/4 fliesst über den Bypass und einen zweiten Einlauf zurück in den Teich. Fliesst das ganze Teichvolumen durch die Kammer, lässt sich die Bakterienzahl noch wenige Prozente mehr drücken. Ich bin der Meinung, ein wenig Reserve schadet nicht.
Wäre die Lampe nicht mehr tauglich, würde sich dies mit der Veränderung der Keimzahl bemerkbar machen. Nach meinen Erfahrungen wird die Keimbelastung im Teichwasser langsam und stetig ansteigen. Nach einem knappen Monat bei Sommertemperatur, inkl. 10% TWW wöchentlich, könnte ich dann in meinem Teich Werte Richtung 100‘000 KBE/ml ermitteln.
Dass die Kontrolle der Keimreduzierung von UV-Lampen funktioniert, zeigt auch unser User wr mit seinen Bildern Seite 1 in diesem Thread.
Die Ermittlung der Keimzahl im Teichwasser sehe ich nicht als „Muss“ in der Koihaltung aber es gibt Sicherheit betreff Funktionalität des eingesetzten Materials. Man erhält eigene Erfahrungswerte die mit Zahlen belegt werden können und die schlussendlich den Koi zu Gute kommen.
Gruss Dany
Ich beende dieses Jahr nun bereits meine 9. Koisaison. Als ich meinen Teich im Herbst 2008 das erste Mal mit Wasser befüllte und im folgenden Frühling mit Koi besetzte, da war die Verunsicherung bei mir gross. Aus der Fachliteratur, der Teichberatungen bei Koihändlern oder aus den vielen Erfahrungsberichten in Foren, interpretierte ich die Koihaltung als eine herausfordernde und anstrengende Gratwanderung. Falsches Handeln am Teich könnte für die Koi verheerende Folgen haben und die Kosten für die Behebung möglicher Fehler beim Teichbau, sowie die Rechnungen tierärztlicher Behandlungen, wären alles andere als entspannend.
Bei meinem ersten Kurs beim FishDoc lernte ich bereits auf dem Parkplatz einen Kursteilnehmer kennen. Dieser berichtete mir über den Tod seines gesamten Koibestandes durch Sauerstoffmangel und dies im ersten Sommer. Ich sah in diesem Moment meine Interpretation über die Koihaltung als bestätigt. Beruhigend war für mich, dass ich selber Kursteilnehmer war und das Gelernte mit bestem Willen auch in die Tat umsetzen wollte. Ja, mit allen guten Vorsätzen……………………………..ich habe schlussendlich doch nicht alles so umgesetzt wie mir empfohlen wurde.
Bei meiner bescheidenen Anlage ist zwar gutes Material im Einsatz aber meine Filteranlage ist nicht „high Tech“. Meine Vorfilterung wird nie Partikel- oder Schwebeteilchen freies Wasser freigeben und der Flow in meinem Teich ist mit 3 Stunden und 20 Minuten überhaupt nicht das, was empfohlen wird. Mein Teichwasser erfüllt aber die Sollwerte der gängigen und wichtigsten Parameter einer Koihaltung.
Es ist nicht so dass meine Filtertechnik eventuelle Abweichungen der Wasserwerte von alleine korrigiert. Ein pflichtbewusstes Teichmanagement lässt mich Verschiebungen frühzeitig erkennen und Gegenmassnahmen einleiten.
Auch die Veränderungen des Keimdruckes im freien Wasser, sei es temperaturbedingt, Futtermenge, Probleme der Vorfilterung oder verbrauchte UV-Lampen, lassen sich mit DipSlides einfach und verlässlich feststellen. Für mich ist es wichtig zu sehen wie meine Anlage arbeitet und so testete ich wieder einmal die Keimbelastungen der Stationen meiner Filterung. Ich erhalte so Daten die mir zeigen ob alles im gewohnten Rahmen abläuft. Diese Stufenkontrolle fasste ich mit je 3 Proben pro Sektor während der Hitzeperiode im August des vergangenen Sommers.
Eindrücklich ist die Belastung des Spülwassers der Filtoclear, die bei mir als Vorfilterung immer noch ihren Dienst leisten. Bei diesen Filtern spüle ich das Wasser mittels Hebelfunktion alle zwei Wochen aus. Gäbe es keine Grobschmutzabsonderung müsste der gesammelte organische Abfall im Teich vermodern und die Keimzahl würde ansteigen.
Verlässt das Wasser die Filtoclear, wird es über zwei Einläufe in die 1. Biokammer geleitet. Um restliche Grobpartikel abzufangen, sind die beiden Einläufe mit Strümpfen versehen. Folgend ist noch eine Japanmatte positioniert, bevor das Wasser die belüfteten und mit Helix befüllten Kammern passiert. Das Wasser der Kammern zeigt sich gleich belastet wie jenes im Teich. Dies beruhigt mich, denn eine hohe Zahl könnte für die Nitrifikanten störend sein.
Die Bakterienbelastung in meiner UV-Kammer zeigt sich tief. Meine Tauch-UVC-eco- Fish 60 Watt Amalgam, senkt die Keimzahl auch mit 10‘230 Betriebsstunden noch einwandfrei. Auf der Skizze ist zu sehen dass ich nicht alles Wasser durch die UV behandeln lasse. 1/4 fliesst über den Bypass und einen zweiten Einlauf zurück in den Teich. Fliesst das ganze Teichvolumen durch die Kammer, lässt sich die Bakterienzahl noch wenige Prozente mehr drücken. Ich bin der Meinung, ein wenig Reserve schadet nicht.
Wäre die Lampe nicht mehr tauglich, würde sich dies mit der Veränderung der Keimzahl bemerkbar machen. Nach meinen Erfahrungen wird die Keimbelastung im Teichwasser langsam und stetig ansteigen. Nach einem knappen Monat bei Sommertemperatur, inkl. 10% TWW wöchentlich, könnte ich dann in meinem Teich Werte Richtung 100‘000 KBE/ml ermitteln.
Dass die Kontrolle der Keimreduzierung von UV-Lampen funktioniert, zeigt auch unser User wr mit seinen Bildern Seite 1 in diesem Thread.
Die Ermittlung der Keimzahl im Teichwasser sehe ich nicht als „Muss“ in der Koihaltung aber es gibt Sicherheit betreff Funktionalität des eingesetzten Materials. Man erhält eigene Erfahrungswerte die mit Zahlen belegt werden können und die schlussendlich den Koi zu Gute kommen.
Gruss Dany
Anhänge
Fred S
Mitglied
Bleib mal ganz locker Dany meine Filteranlage läuft auch nicht so wie es Empfohlen wird und das nun schon seit 12 Jahren. Zumindest was die Umwälzrate und und Nichtbetrieb der UVC betrifft und es funktioniert. Bei meiner Teichgröße würde da eine Menge Strom fließen, was ich als unnötig und reine Geldverschwendung sehe. Aber ich wasche natürlich regelmäßig meine Schwämme aus und spüle die Anlage den irgendwie muss ja der Dreck raus. Mit dem Keimdruck hab ich meine eigene Erfahrung und Meinung die Natur regelt vieles selbst wenn man sie lässt und nicht überfordert.
Wenn man sich Gedanken macht und Wissen aneignet ist das schon ok. Die Meinungen bei diesem Hobby sind sehr unterschiedlich und es führen mehrere Wege zum Erfolg.
Mich würde ja mal in dem Zusammenhang interessieren wie das die Japaner in ihren Schlammteichen mit dem Keimdruck sehen. :wink:
Gruß Fred :lol: :lol:
Wenn man sich Gedanken macht und Wissen aneignet ist das schon ok. Die Meinungen bei diesem Hobby sind sehr unterschiedlich und es führen mehrere Wege zum Erfolg.
Mich würde ja mal in dem Zusammenhang interessieren wie das die Japaner in ihren Schlammteichen mit dem Keimdruck sehen. :wink:
Gruß Fred :lol: :lol:
G
Gelöschtes Mitglied 9419
Guest
Hallo
Keimbelastungen von Wasser sind eine spezielle Sache. In Härtefällen sind diese zwar zu riechen aber von blossem Auge sind solche Verunreinigungen nicht zu erkennen. Wer denkt trübes Wasser kann ja nur stark belastet sein liegt falsch. Wer denkt klares Wasser muss eine tiefe Keimzahl aufweisen liegt komplett falsch.
Auf dem eingestellten Foto sind verschiedene keimbelastete Wasser aufgestellt. Zwar zeigen sich unterschiedliche Färbungen der Proben aber daraus eine Keimzahl zu schätzen oder zu erkennen ist nicht möglich.
Mit brauchbarer und richtig eingesetzter Technik, ist ein bakteriell wenig belasteter Lebensraum unserer Fische zu erreichen. Das heisst, die meisten Koihalter gehen davon aus!
Die von tierärztlicher Seite empfohlene tiefe Keimzahl in Koiteichen, stellt sich berechtigt der Bakterienbelastung des Wassers von den trüben und schlammigen Naturteichen in Japan gegenüber.
Fred S hat hier einen guten Input gegeben.
Ist die Keimbelastung in einer solchen „Schlammpfütze“ den wirklich so hoch oder etwa nicht?
Wenn jemand Infos oder Berichte dazu hat, wäre es schön diese im Keimzahl Thread zu lesen.
Gruss Dany
Keimbelastungen von Wasser sind eine spezielle Sache. In Härtefällen sind diese zwar zu riechen aber von blossem Auge sind solche Verunreinigungen nicht zu erkennen. Wer denkt trübes Wasser kann ja nur stark belastet sein liegt falsch. Wer denkt klares Wasser muss eine tiefe Keimzahl aufweisen liegt komplett falsch.
Auf dem eingestellten Foto sind verschiedene keimbelastete Wasser aufgestellt. Zwar zeigen sich unterschiedliche Färbungen der Proben aber daraus eine Keimzahl zu schätzen oder zu erkennen ist nicht möglich.
Mit brauchbarer und richtig eingesetzter Technik, ist ein bakteriell wenig belasteter Lebensraum unserer Fische zu erreichen. Das heisst, die meisten Koihalter gehen davon aus!
Die von tierärztlicher Seite empfohlene tiefe Keimzahl in Koiteichen, stellt sich berechtigt der Bakterienbelastung des Wassers von den trüben und schlammigen Naturteichen in Japan gegenüber.
Fred S hat hier einen guten Input gegeben.
Ist die Keimbelastung in einer solchen „Schlammpfütze“ den wirklich so hoch oder etwa nicht?
Wenn jemand Infos oder Berichte dazu hat, wäre es schön diese im Keimzahl Thread zu lesen.
Gruss Dany
Anhänge
G
Gelöschtes Mitglied 9419
Guest
Hallo
Ich weiss nicht wie stark die bakteriologische Belastung des Wassers in Mudponds ist. Mit dem schlammigen Grund der von den Fischen durchwühlt wird, kann man sich vorstellen dass dort das Wasser dreckig hoch belastet sein muss.
Um mir ein Bild von einer Durchmischung von Schlamm und Wasser zu machen, füllte ich eine sterile Flasche mit Spülwasser meiner Filtoclear. Ich wollte ein stark belastetes Wasser dessen Partikel sich am Boden absetzen.
Nach 40 Minuten setzte sich das gröbste Material und nach 15 Stunden hatten sich auch die letzten Teilchen auf den Flaschenboden begeben.
Das Wasser zeigte sich nun klar und ich fasste je eine Probe von beiden Schichten. In meinen „Filtereimer“ modert das Wasser bis zur nächsten Spülung vor sich hin und es verwundert nicht, dass sich die Keimbelastung des Bodengrundes mit einer hohen Zahl präsentierte. Der klare Anteil war dagegen erstaunlich tief.
Um die entstehenden Turbolenzen eines gründelnden Koi zu simulieren, drehte ich die Flasche mehrmals. Der Bodensatz verteilte sich dadurch gleichmässig im ganzen Gefäss.
Die Keimzahl dieser Mischung aus Dreck und Wasser verdünnte sich beachtlich. Ehrlich geschrieben, ich hätte nicht gedacht dass der Verdünnungseffekt so gross ist.
In einem Teich mit X – tausend Liter Wasser wird sich der aufgewirbelte Schlamm noch viel mehr verdünnen.
Ich glaube nicht dass die Fische in den Mudponds mit einem sehr hohen Keimdruck konfrontiert werden. Aber eben………ich weiss es nicht!
Gruss Dany
Ich weiss nicht wie stark die bakteriologische Belastung des Wassers in Mudponds ist. Mit dem schlammigen Grund der von den Fischen durchwühlt wird, kann man sich vorstellen dass dort das Wasser dreckig hoch belastet sein muss.
Um mir ein Bild von einer Durchmischung von Schlamm und Wasser zu machen, füllte ich eine sterile Flasche mit Spülwasser meiner Filtoclear. Ich wollte ein stark belastetes Wasser dessen Partikel sich am Boden absetzen.
Nach 40 Minuten setzte sich das gröbste Material und nach 15 Stunden hatten sich auch die letzten Teilchen auf den Flaschenboden begeben.
Das Wasser zeigte sich nun klar und ich fasste je eine Probe von beiden Schichten. In meinen „Filtereimer“ modert das Wasser bis zur nächsten Spülung vor sich hin und es verwundert nicht, dass sich die Keimbelastung des Bodengrundes mit einer hohen Zahl präsentierte. Der klare Anteil war dagegen erstaunlich tief.
Um die entstehenden Turbolenzen eines gründelnden Koi zu simulieren, drehte ich die Flasche mehrmals. Der Bodensatz verteilte sich dadurch gleichmässig im ganzen Gefäss.
Die Keimzahl dieser Mischung aus Dreck und Wasser verdünnte sich beachtlich. Ehrlich geschrieben, ich hätte nicht gedacht dass der Verdünnungseffekt so gross ist.
In einem Teich mit X – tausend Liter Wasser wird sich der aufgewirbelte Schlamm noch viel mehr verdünnen.
Ich glaube nicht dass die Fische in den Mudponds mit einem sehr hohen Keimdruck konfrontiert werden. Aber eben………ich weiss es nicht!
Gruss Dany
Anhänge
Mikrobiologie
Business Mitglied 
Hallo Dany,
Dabei zeigt sich immer ein eindeutiger Trend.
Keimzahlen im Verdauungstrakt > Kiemen > Sediment > Teichwasser.
Vielleicht erkennt so mancher, warum eine UVC mit Spielzeugcharakter wenig beitragen kann zur Keimreduzierung in einem Teich.
Ein Beispiel:
Verdauungstrakt 8.7 ± 4.1×10hoch9 zu 5.4 ± 3.2×10hoch10 cfu/g.
Kiemen 4.3 ± 2.9×10hoch6 zu 1.6 ± 3.9×10hoch7 cfu/g;
Sediment 9.3 ± 2.1×10hoch7 zu 2.7 ± 3.5×10hoch9 cfu/g
Teichwasser 1.2 ± 2.9×10hoch4 zu 2.5 ± 3.5×10hoch5 cfu/mL
Aus der Aquakultur ist längst bekannt, dass der sogenannte Keimdruck nicht immer den Ausbruch von Krankheit erklären kann. Ganz im Gegenteil, man hat noch keine schlüssige Erklärung warum bei sehr niedrigem Keimdruck besonders aktive/agressive Krankheitsausbrüche zu sehen sind.
es gibt genug wissenschaftliche Studien über die bakterielle Belastung von Karpfen in natürlichen Teichen.Dänu schrieb:Ich glaube nicht dass die Fische in den Mudponds mit einem sehr hohen Keimdruck konfrontiert werden. Aber eben………ich weiss es nicht!
Dabei zeigt sich immer ein eindeutiger Trend.
Keimzahlen im Verdauungstrakt > Kiemen > Sediment > Teichwasser.
Vielleicht erkennt so mancher, warum eine UVC mit Spielzeugcharakter wenig beitragen kann zur Keimreduzierung in einem Teich.
Ein Beispiel:
Verdauungstrakt 8.7 ± 4.1×10hoch9 zu 5.4 ± 3.2×10hoch10 cfu/g.
Kiemen 4.3 ± 2.9×10hoch6 zu 1.6 ± 3.9×10hoch7 cfu/g;
Sediment 9.3 ± 2.1×10hoch7 zu 2.7 ± 3.5×10hoch9 cfu/g
Teichwasser 1.2 ± 2.9×10hoch4 zu 2.5 ± 3.5×10hoch5 cfu/mL
Aus der Aquakultur ist längst bekannt, dass der sogenannte Keimdruck nicht immer den Ausbruch von Krankheit erklären kann. Ganz im Gegenteil, man hat noch keine schlüssige Erklärung warum bei sehr niedrigem Keimdruck besonders aktive/agressive Krankheitsausbrüche zu sehen sind.
G
Gelöschtes Mitglied 9419
Guest
Hallo
Wenn ich die Zahlen richtig verstehe, ist aus dem Beitrag von Mikrobe zu entnehmen dass Naturteiche verschieden belastet sein können. Werte von wenigen 10‘000 KBE/ml bis mehreren 100‘000 KBE/ml sind je nach Teich möglich.
Ich habe einen Waldteich in meiner Nähe aufgesucht, der mindestens eine solche Trübung aufweist wie viele solcher Mudponds in Japan und in dem auch einige Karpfen genüsslich ihre Runden schwimmen.
Zuerst fasste ich eine Probe des stillen und trüben Wassers. Danach „stocherte“ ich mit einer Schaufel in den Bodengrund und fasste eine zweite Wasserprobe mit aufgewirbeltem Sediment. Als weiteres schaufelte ich Bodengrund oder eben Schlamm aus diesem Naturteich in einen Eimer. Nach knappen 30 Minuten waren die Proben angesetzt inklusive anaerober Keime des Schlammes.
Wieder zu Hause füllte ich das Gesammelte in ein Aquarium um die Schichten besser zu erkennen. Trotz der grossen Trübung im Teich selber, war im Gefäss doch noch eine erstaunliche Sichtweite zu erkennen. Auf den Fotos setzte ich dann die ermittelten Keimzahlen des Waldteiches ein.
Das Wasser wies eine tiefe Zahl auf und auch der doppelte Wert des Gemisches von Wasser und Bodengrund von 24‘000 Kolonien pro Milliliter, lag im Bereich eines gut geführten Koiteiches. Der Schlamm mit der Zahl von 600‘000 war auch nicht abartig dreckig. Zum Vergleich erinnere ich gerne an den Mischsalat der bei der Beprobung des deutschen Warentests, zum Teil Zahlen von mehreren 100 Millionen KBE/g aufwies.
Natürlich ist dies kein Mudpond aber die Zahlen stammen aus einem schlammigen und trüben Waldteich mit Karpfen mitten in der Natur. Der Schlamm färbt das Wasser!
Gruss Dany
Wenn ich die Zahlen richtig verstehe, ist aus dem Beitrag von Mikrobe zu entnehmen dass Naturteiche verschieden belastet sein können. Werte von wenigen 10‘000 KBE/ml bis mehreren 100‘000 KBE/ml sind je nach Teich möglich.
Ich habe einen Waldteich in meiner Nähe aufgesucht, der mindestens eine solche Trübung aufweist wie viele solcher Mudponds in Japan und in dem auch einige Karpfen genüsslich ihre Runden schwimmen.
Zuerst fasste ich eine Probe des stillen und trüben Wassers. Danach „stocherte“ ich mit einer Schaufel in den Bodengrund und fasste eine zweite Wasserprobe mit aufgewirbeltem Sediment. Als weiteres schaufelte ich Bodengrund oder eben Schlamm aus diesem Naturteich in einen Eimer. Nach knappen 30 Minuten waren die Proben angesetzt inklusive anaerober Keime des Schlammes.
Wieder zu Hause füllte ich das Gesammelte in ein Aquarium um die Schichten besser zu erkennen. Trotz der grossen Trübung im Teich selber, war im Gefäss doch noch eine erstaunliche Sichtweite zu erkennen. Auf den Fotos setzte ich dann die ermittelten Keimzahlen des Waldteiches ein.
Das Wasser wies eine tiefe Zahl auf und auch der doppelte Wert des Gemisches von Wasser und Bodengrund von 24‘000 Kolonien pro Milliliter, lag im Bereich eines gut geführten Koiteiches. Der Schlamm mit der Zahl von 600‘000 war auch nicht abartig dreckig. Zum Vergleich erinnere ich gerne an den Mischsalat der bei der Beprobung des deutschen Warentests, zum Teil Zahlen von mehreren 100 Millionen KBE/g aufwies.
Natürlich ist dies kein Mudpond aber die Zahlen stammen aus einem schlammigen und trüben Waldteich mit Karpfen mitten in der Natur. Der Schlamm färbt das Wasser!
Gruss Dany
Anhänge
Ähnliche Themen
- Antworten
- 0
- Aufrufe
- 308